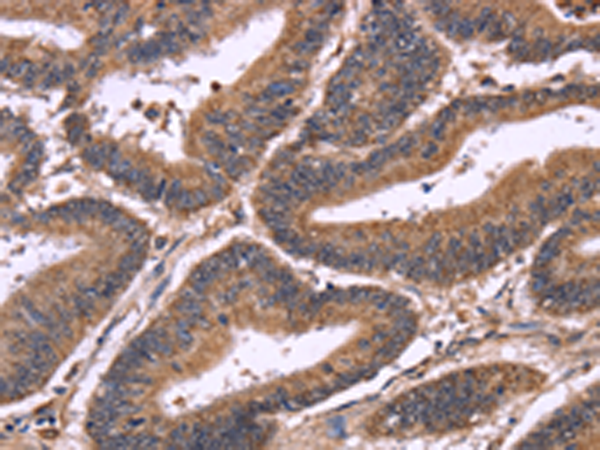

中文名稱:兔抗SEPTIN7多克隆抗體
英文名稱: Anti-SEPTIN7 rabbit polyclonal antibody
別 名: septin 7; CDC3; CDC10; SEPT7; SEPT7A; NBLA02942
相關類別: 一抗
儲 存: 冷凍(-20℃)
宿 主: Rabbit
反應種屬: Human, Mouse, Rat
標記物: Unconjugate
克隆類型: rabbit polyclonal
技術規格
|
Background: |
This gene encodes a protein that is highly similar to the CDC10 protein of Saccharomyces cerevisiae. The protein also shares similarity with Diff 6 of Drosophila and with H5 of mouse. Each of these similar proteins, including the yeast CDC10, contains a GTP-binding motif. The yeast CDC10 protein is a structural component of the 10 nm filament which lies inside the cytoplasmic membrane and is essential for cytokinesis. This human protein functions in gliomagenesis and in the suppression of glioma cell growth, and it is required for the association of centromere-associated protein E with the kinetochore. Alternative splicing results in multiple transcript variants. Several related pseudogenes have been identified on chromosomes 5, 7, 9, 10, 11, 14, 17 and 19. [provided by RefSeq, Jul 2011] |
|
Applications: |
ELISA, WB, IHC |
|
Name of antibody: |
SEPTIN7 |
|
Immunogen: |
Fusion protein of human SEPTIN7 |
|
Full name: |
septin 7 |
|
Synonyms: |
CDC3; CDC10; SEPT7; SEPT7A; NBLA02942 |
|
SwissProt: |
Q16181 |
|
IHC positive control: |
Human colon cancer and Human liver cancer |
|
IHC Recommend dilution: |
100-300 |
|
WB Predicted band size: |
51 kDa |
|
WB Positive control: |
Hela cells |
|
WB Recommended dilution: |
500-2000 |

購物車
購物車 幫助
幫助
 021-54845833/15800441009
021-54845833/15800441009
